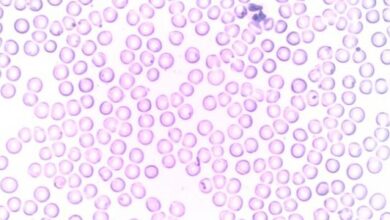

محتويات

تحليل فيروس سي، أو تحليل فيروس C، أو تحليل فيروس ج، أو تحليل التهاب الكبد C، أو تحليل فيروس التهاب الكبد الوبائيّ C (بالإنجليزية: Hepatitis C) هو مجموعةٌ من التحاليل والاختبارات التشخيصيّة التي يتمّ إجراؤها لتشخيص الإصابة بعدوى فيروس سي، والمساعدة على تحديد ومتابعة الخطّة العلاجيّة للمرض، إذ تؤدي الإصابة بعدوى فيروس سي إلى حدوث ضررٍ والتهابٍ في الكبد، وينتمي فيروس سي لمجموعة الفيروسات المسبّبة لالتهاب الكبد؛ وهي فيروس أ، ب، سي، د، هـ، وتنتقل عدوى فيروس سي عن طريق دم الشخص المصاب؛ بشكلٍ رئيسيّ عبر مشاركة الإبر والحُقن الوريديّة مع الشخص المصاب، وتنتقل بنسبةٍ أقل عن طريق ممارسة العلاقة الجنسيّة مع الشخص المصاب، ومشاركة بعض الأدوات الشخصيّة التي تكون ملوثةً بدم المصاب مثل: شفرات الحلاقة، وفرشاة الأسنان، وبين الأم الحامل المصابة والجنين، ورسم الوشم، وتعرُّض بعض مقدمي الرعاية الصحية لوخزة الإبرة عن طريق الخطأ من إحدى الحقن المستخدمة لحقن أحد المصابين.[١]
تتضمن تحاليل واختبارات فيروس التهاب الكبد الوبائي سي ما يأتي:
يكشف تحليل الأجسام المضادّة في الدم (بالإنجليزية: Antibody blood test) عن التعرّض لعدوى فيروس التهاب الكبد سي خلال أيّ من مراحل العُمُر المختلفة، وذلك من خلال الكشف عن وجود الأجسام المضادّة للفيروس في الدم، إذ يتم إنتاجها من الجهاز المناعيّ لمحاربة مسببات المرض، وهي فيروس سي في هذه الحالة، ويُشار إلى أنّ الأجسام المضادة قد تحتاج إلى مدةٍ للظهور في الدم وقد يتأخر إنتاجها من الجهاز المناعيّ، وبالتالي لا يكشف التحليل الإصابة في حال التعرض للفيروس قبل فترة بسيطة من إجراء الفحص؛ أي أنّ نتائج هذا التحليل تُظهر ما إذا تم التعرض للإصابة سابقًا دون تحديد وقت الإصابة، ولا يمكن أيضًا معرفة إذا تمّ الشفاء من العدوى باستخدام هذا التحليل، وذلك لأنّ الأجسام المضادة تظل لفترة طويلة في الدم حتى وإن شُفي المصاب من العدوى.[٢][٣]
يكشف تحليل الحمض النووي لفيروس التهاب الكبد سي (بالإنجليزية: HCV genetic material testing) عن وجود المادّة الوراثيّة للفيروس في الدم، وفي هذه الحالة هي الحمض النووي الريبوزيّ (بالإنجليزية: RNA)، ويعتمد هذا التحليل على تقنيّة تفاعل البوليميراز المتسلسل (بالإنجليزية: Polymerase chain reaction) واختصارًا PCR للكشف عن العدوى النشطة أو الحاليّة بفيروس سي.، ويُشار إلى أنّ الحمض النوويّ الريبوزيّ للفيروس يظهر في الدم خلال مدّةٍ تصل إلى أسبوعين تقريبًا بعد التعرض للفيروس،[٤][٥] ويوجد نوعان لهذا التحليل، وفيما يأتي بيانهما:[١]
- تحليل الحمض النوويّ الكميّ: (بالإنجليزية: RNA Quantitative test)؛ يقيس هذا التحليل ويكشف عن الحِمل الفيروسيّ (بالإنجليزية: Viral load) وهو كمية الحمض النووي الريبوزي للفيروس في الدم.
- تحليل الحمض النوويّ النوعيّ: (بالإنجليزية: RNA Qualitative test)؛ يتمّ إجراؤه للتمييز بين الإصابة الحاليّة أو السابقة بالفيروس، وذلك عن طريق الكشف عن وجود الحمض النووي الرايبوزي للفيروس في الدم، ففي حال وجود نسبةٍ للفيروس يستطيع قياسها يعطي نتيجةً إيجابيةً، وغير ذلك يعطي نتيجةً سلبيةً، وتجدر الإشارة إلى أنّه لم يَعد يُستخدم هذا التحليل في أغلب الأحيان.
تحليل مستضد فيروس سي، أو تحليل مولد الضد لفيروس سي (بالإنجليزية: HCV Antigen test)؛ يتشابه هذا التحليل مع تحليل الحمض النووي فكلاهما يكشف عن وجود الفيروس في دم المصاب؛ ولكن في هذه الحالة يتمّ الكشف عن مولد الضد (بالإنجليزية: Antigen) للفيروس وهو أحد أجزاء الفيروس بدلًا من المادة الوراثية التي يتم الكشف عنها في تحليل الحمض النووي، ويساهم هذا التحليل في الكشف عن الإصابة الحاليّة بالفيروس؛ لكن لا يعد استخدام هذا التحليل شائعًا.[٦]
تحليل النمط الوراثيّ لفيروس سي (بالإنجليزية: HCV genotype)؛ يكشف هذا التحليل عن النوع أو النمط الوراثي للفيروس؛ إذ تمّ اكتشاف 6 سلالاتٍ رئيسيّةٍ للفيروس، وما يزيد عن 50 سُلالةٍ فرعيّةٍ، وأكثرها شيوعًا؛ سُلالة النمط الوراثيّ 1، ويساهم هذا التحليل في تحديد العلاج المناسب، واختيار الدواء المناسب من مجموعة الأدوية التي تعمل بشكلٍ مباشرٍ على الفيروس (بالإنجليزية: Direct acting antivirals) واختصارًا DAAs،[١][٧] وهي عبارة عن أدوية تستهدف مراحل معينةٍ من دورة حياة الفيروس لإيقاف تضاعف الفيروس.[٨]
تحليل مقاومة فيروس سي (بالإنجليزية: HCV resistance testing)؛ يُجرى عند معظم المصابين في حال عدم نجاح العلاج بأحد أنواع الأدوية التي تستهدف الفيروس بشكلٍ مباشرٍ، وذلك قبل البدء بتجربة نوع آخر من هذه الأدوية للكشف عن مقاومة الفيروس.[٨]
لا تحتاج تحاليل فيروس سي أيّ تحضيراتٍ في الغالب، ويُشار إلى ضرورة إعلام الطبيب قبل إجراء التحليل في حال استخدام أيّ من الأدوية بما فيها التي لا تحتاج وصفةً طبيّةً، وجميع المكمّلات الغذائيّة والأعشاب والفيتامينات، وأيضًا في حال استخدام أيّ أدويةٍ غير مشروعةٍ.[٩]
يُجرى التحليل بسحب عيّنة دمٍ من الشخص المعني،[٩] ويمكن توضيح خطواتها على النحو الآتي:[١٠]
- لفّ أعلى الذراع بشريطٍ مطاطيّ؛ لإيقاف تدفّق الدم وبالتالي زيادة حجم الأوردة أسفل الشريط، مما يسهل وخز الإبرة في الوريد.
- تعقيم منطقة الحقن بالكحول الطبيّ.
- وخز الإبرة في الوريد، وقد تتمّ إعادة العملية لإيجاد المكان المناسب باستخدام إبرةٍ جديدةٍ.
- ملء الأنبوب بالدم المسحوب من الوريد.
- إزالة الشريط المطاطيّ عن الذراع بعد سحب كميّةٍ كافيةٍ من الدم.
- وضع قطعةٍ من الشاش أو القطن على موضع وخز الإبرة أثناء سحبها من الجلد.
- تطبيق ضغطٍ خفيفٍ على منطقة الحقن ووضع الضماد بعد إزالة الإبرة.
تظهر نتائج تحليل فيروس سي عادةً خلال 5-7 أيّامٍ،[١١] وفيما يأتي بيان تفسير نتائج التحاليل المختلفة لفيروس سي:
- تفسير نتائج تحليل الأجسام المضادة: يُعبّر عنه بنتيجةٍ (إيجابيةٍ) أو (سلبيّةٍ)، وفيما يأتي تفسير نتائج التحليل:[٣][١]
- النتيجة الإيجابيّة: تعني الإصابة بالفيروس في إحدى مراحل الحياة دون تأكيد وقت الإصابة.
- النتيجة غير الحاسمة: (إيجابية ضعيفة) وغالبًا ما تكون ناجمةً عن خطأ في التحليل، ويتمّ في العادة إعادة التحليل قبل تقديم النتائج الأخيرة للشخص.
- النتيجة السلبية: تعني عدم الكشف عن وجود أجسامٍ مضادةٍ في الدم وذلك يحتمل عدم الإصابة بالمرض، أو الإصابة بالعدوى قبل مدةٍ قصيرةٍ؛ إذ قد تحتاج الأجسام المضادة إلى فترةٍ للظهور في الدم والتمكن من كشف وجودها كما ذكرنا.
- تفسير نتائج تحليل الحمض النووي: بالنسبة لنتائج تحليل الحمض النووي النوعي؛ فالنتيجة الإيجابية تدل على الإصابة الحالية بالفيروس، وفي حال لم يُكتشف الفيروس بالتحليل فقد يدل ذلك على عدم الإصابة بالفيروس في الوقت الحالي، أو وجود نسبةٍ ضئيلةٍ جدًا للفيروس في الدم لا يمكن كشفها بالتحليل.[١] وأمّا نتائج الحمل الفيروسي فيتم التعبير عنها
بعدد نُسخ الفيروس الموجودة في الدم، وفي حال تم استخدام هذا التحليل للكشف عن الإصابة الحالية بالفيروس ولم يتم الكشف عن أيّ فيروسات في الدم أو عددها قليلٌ جدًا فيُظهر التحليل نتيجةً سلبيّةً، كما تدل نتائج تحليل الحمل الفيروسي على فعالية العلاج المستخدم في حال الإصابة، وفيما يأتي توضيح تلك النتائج:[١]
- الحمل الفيروسيّ المنخفض أو المتناقص أو غير الملحوظ يدلّ في الغالب على فعالية العلاج.
- الحمل الفيروسي المرتفع أو المتزايد يدل على عدم فعالية العلاج وعدم استجابة المريض.
- الحمل الفيروسي غير المكتشف بالتحليل بعد انتهاء العلاج يدل على نجاحه، وعدم اكتشاف أي وجودٍ للحمل الفيروسي في الدم بعد ثلاثة أشهر من انتهاء العلاج يدل على الشفاء التام واستجابة الفيروس للعلاج.
- تفسير نتائج تحليل النمط الوراثي: يعتمد تحديد العلاج على صحة الكبد والنمط الوراثي للفيروس، وتحدد نتائج هذا التحليل سُلالة الفيروس سي المسبب لالتهاب الكبد، كما يساعد في تحديد العلاج ومدة العلاج.[١]
ويمكن توضيح نتائج تحليلي الأجسام المضادّة والمادة الوراثيّة عند إجرائهما معًا من خلال الجدول الآتي:[١]
| تحليل الأجسام المضادة | تحليل المادة الوراثية | التفسير |
|---|---|---|
| سلبية | – | عدم وجود عدوى، أو إجراء التحليل بعد فترةٍ بسيطةٍ من التعرض للفيروس وقبل ظهور الأجسام المضادّة، وفي هذه الحالة قد يُطلب إجراء تحليل المادة الوراثيّة في حال الاشتباه الشديد بالإصابة. |
| سلبية | إيجابية | عدوى حادّة بالتهاب الكبد سي. |
| إيجابية أو شبه إيجابية | سلبية | إصابة سابقة بالعدوى أو عدم وجود إصابة. |
| إيجابية | إيجابية | عدوى حاليّة نشطة. |
تقتصر الآثار الجانبية لتحليل فيروس سي على الآثار المترتبة على عملية سحب الدم؛ فقد يصاحب وخز الإبرة شعورٌ بسيطٌ بالألم أو اللسع، وقد يؤدي إلى الشعور بألمٍ وتقرّحٍ في موضع الإبرة، ومن الآثار الجانبية النادرة التي قد تصاحب التحليل ما يأتي:[٩]
- النزيف.
- ظهور الكدمات
- الإصابة بالعدوى.
- الدوخة.
من الحالات التي تستدعي إجراء أحد تحاليل فيروس سي ما يأتي:
يُنصح جميع الأشخاص الذين تتراوح أعمارهم بين 18-79 سنة بإجراء الفحص للكشف عن الإصابة بعدوى فيروس سي، حتى في حال عدم وجود أعراضٍ للإصابة، أو أمراضٍ معروفةٍ في الكبد، كما يُنصح بذلك لجميع النساء عند الحمل، ولأيّ شخصٍ يطلب إجراء التحليل، ويُشار إلى ضرورة إجراء الفحص في حال ارتفاع خطر التعرُّض للفيروس، وإجراء الفحص بشكلٍ دوريّ في حال استمرار خطر الإصابة بالعدوى؛ كأثناء فترة استخدام الأدوية التي تُعطى عن طريق الحقن،[١٢][١] وإنّ وجود أحد عوامل الخطورة لدى الفئات التي سيتم ذكرها لا يعني بالضرورة الإصابة بعدوى فيروس سي؛ وإنّما تزيد تلك العوامل من خطر الإصابة فقط مقارنةً بمن لا يمتلكها،[١٣] ومن الفئات التي يرتفع لديها خطر الإصابة بفيروس سي ما يأتي:[١٢]
- طفلٌ مولودٌ لأمٍ مصابةٍ بعدوى فيروس سي.
- الاستخدام المسبق لأيّ أدويةٍ غير مشروعةٍ تُحقن في الجلد أو تم استنشاقها.
- ظهور نتائج غير طبيعيةٍ لتحليل وظائف الكبد دون وجود سببٍ واضحٍ.
- مقدمو الرعاية الصحيّة عند تعرضهم لوخزة الإبرة الملوثة بدم أحد المصابين أو التعرض المباشر لدم المصاب.
- الأشخاص مواليد الفترة بين 1945-1965.
- الخضوع لعلاج غسيل الكلى لفترةٍ طويلةٍ.
- الأشخاص الحاصلون على دمٍ منقولٍ، أو الخاضعون لزراعة أحد الأعضاء قبل سنة 1992.
- تشخيص إصابة أحد الزوجين بعدوى فيروس سي.
- أخذ أحد مركّزات عوامل التخثّر (بالإنجليزية: Clotting factor concentrates) المصنعة قبل عام 1987.[١٤]
- الحصول على دمٍ منقولٍ من شخص تمّ تشخيص إصابته بالفيروس مؤخرًا.[١٤]
- الأشخاص المصابون بعدوى التهاب الكبد ب (بالإنجليزية: Hepatitis B)، أو عدوى فيروس العوز المناعيّ البشريّ (بالإنجليزية: Human immunodeficiency virus) واختصارًا HIV والمسبب لمرض الإيدز.[١٥]
- العيش أو تلقي العلاج الطبي في إحدى المناطق التي تنتشر فيها عدوى فيروس سي بشكلٍ شائعٍ، مثل: الشرق الأوسط، وشمال أفريقيا، ووسط وشرق آسيا.[٢]
- وضع وشم على الجسم باستخدام معداتٍ غير معقمةٍ بطريقةٍ صحيحةٍ.[٢]
- وجود تاريخٍ مسبقٍ للإصابة بأحد الأمراض المنقولة جنسيًا.[١٦]
- استخدام الأدوات الطبيّة غير المعقّمة.[١٧]
- مشاركة الأدوات المستخدمة في حقن الأدوية؛ كالإبر والحقن.[١٧]
- إرضاع المرأة المصابة لطفلها مع وجود تشققٍ ونزيفٍ لحلمة الثدي.[١٧]
- مشاركة أدوات الحلاقة أو الأدوات الشخصيّة الأخرى مع أحد الأشخاص المصابين.[١٧]
فيما يأتي بيان دواعي اللجوء لاختبارات تشخيص الإصابة بفيروس سي بحسب نوعها:
- دواعي إجراء تحليل الأجسام المضادة: يُجرى تحليل الأجسام المضادّة لفيروس سي في حال ملاحظة بعض الأعراض التي قد تدلّ على تضرّر الكبد أو التهاب الكبد أو كليهما معًا، أو في حال ظهور نتائج غير طبيعيّةٍ عند إجراء تحليل وظائف الكبد، وفي هذه الحالات قد يُجرى هذا التحليل كجزءٍ من اختبارات الكشف عن التهاب الكبد الحاد، ويُشار إلى أنّه في المراحل الأولى من المرض عند معظم المصابين قد لا تظهر أيّ أعراضٍ للإصابة بالعدوى أو تكون طفيفةً لدرجةٍ قد لا تستدعي مراجعة الطبيب لفحص العدوى بفيروس سي،[١٨] وفيما يأتي بيان بعض الأعراض التي قد تصاحب الإصابة بعدوى فيروس سي في المراحل الأولى:[١]
- دواعي إجراء تحليل الحمض النوويّ لفيروس التهاب الكبد سي: يوجد نوعان من التحاليل يندرجان تحت هذا التحليل، وقد ذُكر سابقًا أنّ تحليل الحمض النووي النوعي يستخدم للتمييز بين الإصابة الحالية أو السابقة بالعدوى؛ بينما تحليل الحمض النووي الكمي قد يُطلب إجراؤه في الحالات الآتية:[١]
- تأكيد وتشخيص الإصابة الحالية بالفيروس بعد ظهور نتيجةٍ إيجابيّةٍ لتحليل الأجسام المضادّة.
- يُجرى كتحليلٍ أوليّ في المراحل المبكرة من الإصابة الحادّة بفيروس التهاب الكبد سي.
- يُجرى في حال الاشتباه الشديد بالإصابة خلال فترةٍ قريبةٍ، أو التعرض مؤخرًا للفيروس المسبب للعدوى خلال آخر شهرين، وذلك بغض النظر عن نتائج تحليل الأجسام المضادة؛ فقد يُظهر نتيجةً سلبيّةً بالرغم من الإصابة في بعض الأحيان؛ لأن الأجسام المضادّة قد لا تظهر قبل شهرين في الدم بعد التعرض للفيروس.
- المساعدة على تحديد مقدار استجابة المصاب للعلاج في حال الإصابة بالتهاب الكبد المزمن سي؛ وذلك بمقارنة نسبة الفيروس في الدم بإجراء التحليل مع بدء العلاج، وخلاله بشكلٍ دوريّ لمراقبة تقدم حالة المصاب، وبعد انتهاء العلاج بما يقارب 3 أشهر للتأكد من الشفاء التامّ من العدوى.
- دواعي إجراء تحليل النمط الوراثيّ لفيروس سي: يُجرى هذا التحليل عند تشخيص الإصابة بعدوى فيروس سي المزمنة، وعند بدء الخضوع للعلاج.[١]
يُجرى هذا التحليل لفحص الإصابة بفيروس التهاب الكبد الوبائي من النوع (C)تعرف أكثر على هذا التحليل:
- ^ أ ب ت ث ج ح خ د ذ ر ز س “Hepatitis C Testing”, labtestsonline.org,10-7-2020، Retrieved 7-1-2021. Edited.
- ^ أ ب ت “Hepatitis C”, www.nhs.uk, Retrieved 7-1-2021. Edited.
- ^ أ ب “health/hepatitis-c-antibody#antibody-test”, www.healthline.com, Retrieved 7-1-2021.Edited.
- ↑ “Testing for hepatitis C”, www.hepctrust.org.uk, Retrieved 7-1-2021. Edited.
- ↑ “Hepatitis C Virus Tests”, www.cigna.com,23-9-2020، Retrieved 7-1-2021. Edited.
- ↑ “Hepatitis C virus”, www.labtestsonline.org.au, Retrieved 7-1-2021. Edited.
- ↑ “Testing for hepatitis C”, www.hepatitisaustralia.com,3-9-2020، Retrieved 7-1-2021. Edited.
- ^ أ ب “Hepatitis C”, www.hepatitis.va.gov, Retrieved 7-1-2021. Edited.
- ^ أ ب ت “Hepatitis C Antibody”, www.urmc.rochester.edu, Retrieved 7-1-2021. Edited.
- ↑ “Hepatitis C Virus Tests”, www.healthlinkbc.ca,26-1-2020، Retrieved 7-1-2021. Edited.
- ↑ “Hepatitis C Virus Tests Results”, www.healthlinkbc.ca,26-1-2020، Retrieved 7-1-2021. Edited.
- ^ أ ب “Hepatitis C”, www.mayoclinic.org,20-3-2020، Retrieved 7-1-2021. Edited.
- ↑ “conditions/hepatitis-a-b-c/screening”, nyulangone.org, Retrieved 7-1-2021.Edited.
- ^ أ ب “Hepatitis C Diagnosis and Tests”, www.webmd.com, Retrieved 7-1-2021. Edited.
- ↑ “Screening and diagnosis of HCV “, www.hepcguidelines.org.au, Retrieved 7-1-2021. Edited.
- ↑ “Hepatitis C Testing”, www.doh.wa.gov, Retrieved 7-1-2021. Edited.
- ^ أ ب ت ث Lori Smith (5-5-2020), “When to get tested for hepatitis C after exposure”، www.medicalnewstoday.com, Retrieved 7-1-2021. Edited.
- ↑ “Hepatitis C Testing”, www.msdmanuals.com, Retrieved 7-1-2021. Edited.